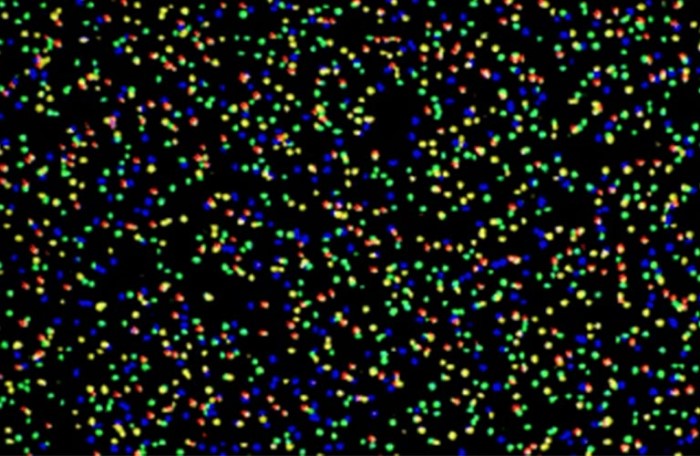

Рекомендуемая компанией Hamamatsu продукция для секвенирования ДНК
Секвенсоры ДНК автоматически расшифровывают базовые последовательности ДНК, которые содержат генетическую информацию живых организмов. Для различных исследовательских целей и, в частности, в области лечения рака, крайне важно быстро и в то же время всесторонне анализировать генетическую информацию. В этом смысле секвенсоры ДНК вносят основной вклад в разработку лекарств и открытие новых лекарственных форм.
Одним из методов декодирования базовых последовательностей является флуоресцентная маркировка каждого из четырех нуклеотидов (A, C, G и T) путем обнаружения чрезвычайно слабого света (флуоресценции), испускаемого базовыми последовательностями. Компания Hamamatsu предлагает линейку высокочувствительных датчиков изображения и камер, включая секвенсоры ДНК, которые оптимальны для обнаружения чрезвычайно слабого света.
Рекомендуемая продукция Hamamatsu:
Серия MPPC S13360
Серия S13360 от Hamamatsu состоит из MPPC для прецизионных измерений. MPPC унаследовали превосходные характеристики предыдущих устройств с низким уровнем послеимпульсного излучения и, кроме того, обеспечивают более низкие перекрестные помехи и меньшее количество затемнений. Они подходят для высокоточных измерений, таких как секвенирование ДНК, для которых требуются характеристики с низким уровнем шума.
Модуль MPPC серии C13365
Серия C13365 от Hamamatsu состоит из оптических измерительных модулей, способных обнаруживать слабый уровень освещенности.
ПЗС сенсоры серии S10140/S10141
Серии S10140 и S10141 (-01) от Hamamatsu представляют собой ПЗС сенсоры с обратным прореживанием, разработанные для обнаружения в условиях низкой освещенности.
Бескорпусная КМОП камера
C11440-52U30 - это компактная и высокочувствительная бескорпусная камера от компании Hamamatsu с новейшим научным КМОП сенсором. Устройство может быть настроено в соответствии с потребностями пользователя.
Бескорпусная TDI камера
C10000-A01 - это настольная камера от компании Hamamatsu, позволяющая получать широкий спектр изображений с более высокой скоростью и чувствительностью. Это достигается за счет синхронизации движения объекта с передачей заряда ПЗС-матрицы. Эта настольная камера используется в приложениях, требующих высокоскоростного обнаружения чрезвычайно слабого света, таких как анализаторы и устройства формирования изображений.
Научные КМОП камеры
Научные КМОП камеры от компании Hamamatsu обладают высокой чувствительностью и низким уровнем шума, что делает их оптимальными для наблюдения при очень слабом освещении. Устройство может быть настроено в соответствии с потребностями пользователя.
Камера TDI
C10000-801 - это камера от компании Hamamatsu, позволяющая получать широкий спектр изображений с более высокой скоростью и чувствительностью. Это достигается за счет синхронизации движения объекта с передачей заряда ПЗС-матрицы. Эта камера используется в приложениях, требующих высокоскоростного обнаружения чрезвычайно слабого света, таких как анализаторы и устройства формирования изображений.
